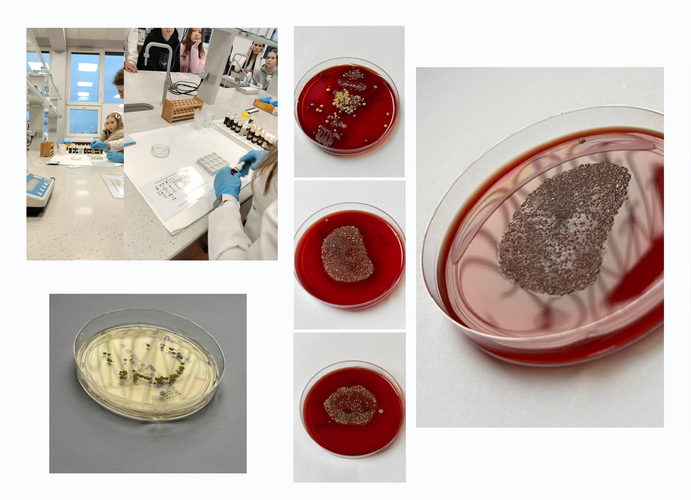

Warsztaty dla uczniów w GUMed
28.01.2025
Uczniowie ósmej klasy szkoły podstawowej im. Karola Wojtyły w Rotmance uczestniczyli 15 stycznia br. w warsztatach zorganizowanych w Katedrze i Zakładzie Toksykologii Gdańskiego Uniwersytetu Medycznego oraz w Katedrze i Zakładzie Mikrobiologii Farmaceutycznej GUMed. 19 uczniów w ramach zajęć wzięło udział w krótkim seminarium na temat szkodliwości substancji psychoaktywnych oraz poznali zasadę działania testów narkotykowych i sposoby wykrywania substancji psychoaktywnych. W ramach wizyty uczniowie mieli też okazję zwiedzić laboratoria Katedry i Zakładu Toksykologii GUMed i poznać podstawowe wyposażenie laboratorium analitycznego.
W ramach zajęć przeprowadzonych w Katedrze i Zakładzie Mikrobiologii Farmaceutycznej GUMed uczniowie wysłuchali wykładu na temat historii mikrobiologii i znaczenia mikroorganizmów dla człowieka i środowiska oraz zapoznali się z podstawowymi technikami pracy mikrobiologicznej. Na diagnostycznych podłożach bakteriologicznych wykonali odciski palców i przedmiotów takich jak: telefony, kolczyki, zegarki. Wyniki tych posiewów zostały utrwalone w formie fotografii, które zostaną przesłane uczestnikom.
Zajęcia w Katedrze i Zakładzie Toksykologii GUMed były prowadzone przez dr Małgorzatę Wacławik, a w Katedrze i Zakładzie Mikrobiologii Farmaceutycznej GUMed przez dr Marię Bartoszewicz i dr Jolantę Ficińską-Mazurczyk.
Program współpracy ze szkołami średnimi jest akcją promocyjną koordynowaną przez dziekan Wydziału Farmaceutycznego prof. dr hab. Magdalenę Prokopowicz oraz dr hab. Małgorzatę Grembecką, prof. uczelni, pełnomocnika Dziekana ds. współpracy ze szkołami.
Ilustracja: Agata Zygadło/Lidia Rybak
Archiwum
- Rok akademicki 2024/2025
- Rok akademicki 2023/2024
- Rok akademicki 2022/2023
- Rok akademicki 2021/2022
- Rok akademicki 2020/2021
- Rok akademicki 2019/2020
- Rok akademicki 2018/2019
- Rok akademicki 2017/2018
- Rok akademicki 2016/2017
- Rok akademicki 2015/2016
- Rok akademicki 2014/2015
- Rok akademicki 2013/2014
- Rok akademicki 2012/2013
- Rok akademicki 2011/2012
- Rok akademicki 2010/2011
- Rok akademicki 2009/2010
- Rok akademicki 2008/2009
- Rok akademicki 2007/2008
- Inauguracje roku akademickiego